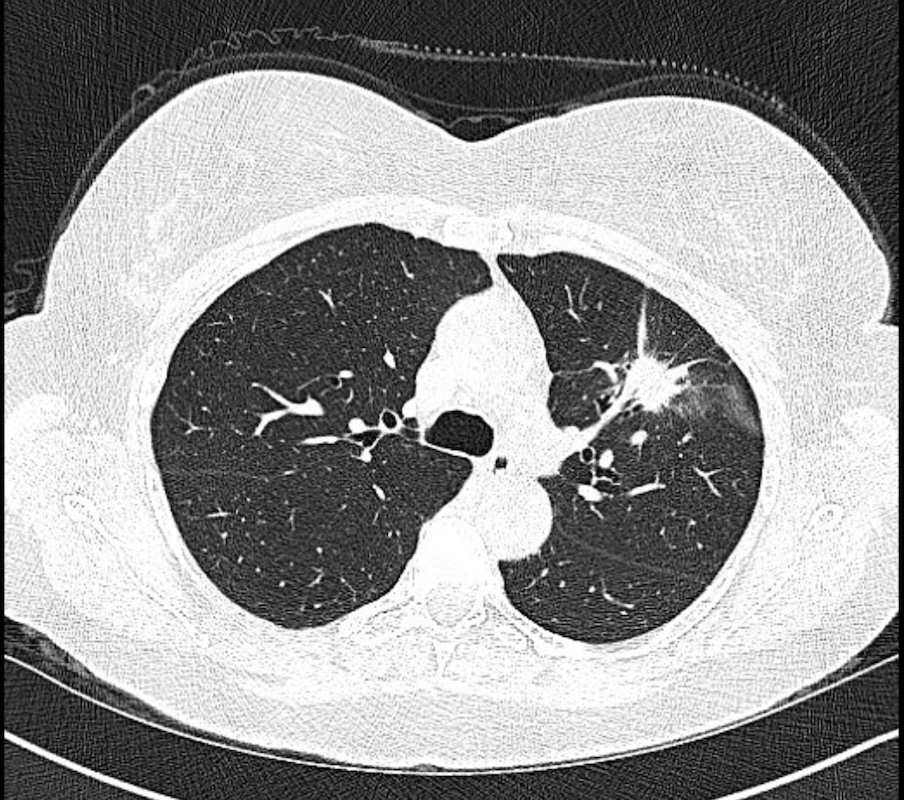
GS_Bronch tweet media
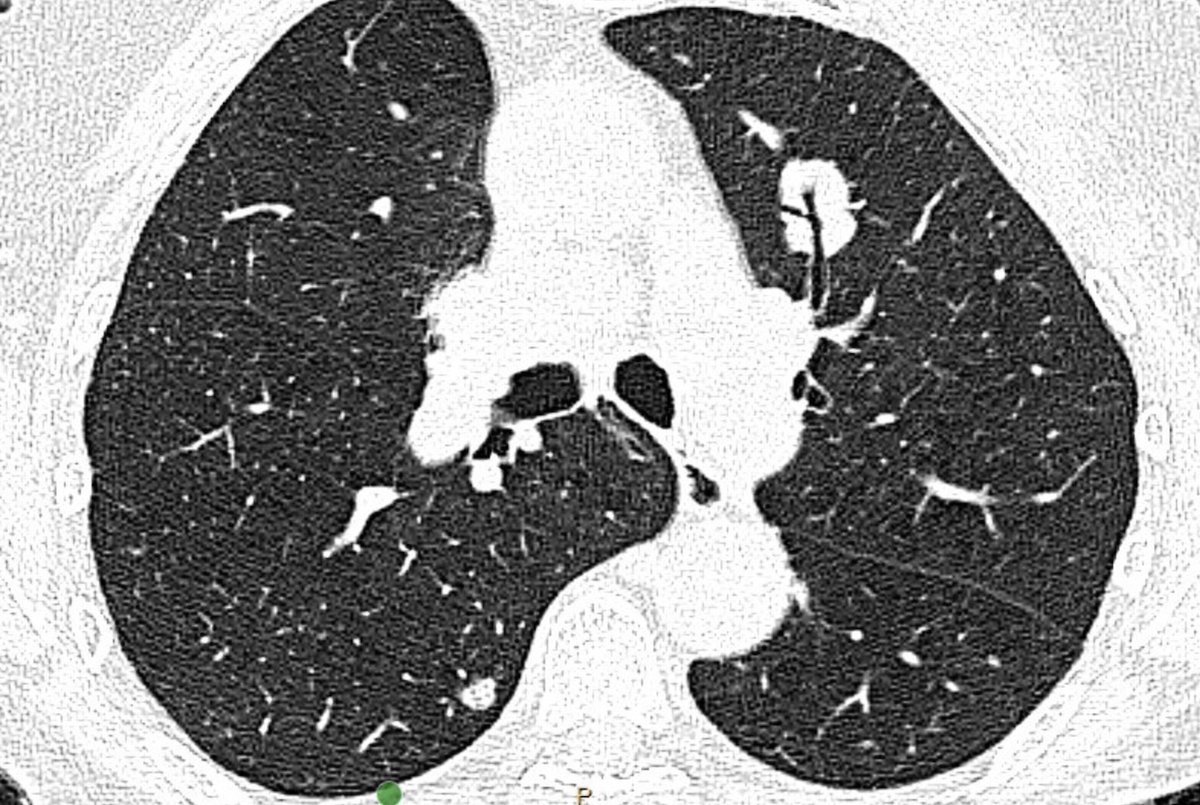
GS_Bronch tweet media

GS_Bronch
21 posts

GS_Bronch retweetledi

A multicenter prospective study of robotic-assisted bronchoscopy shows that RAB-guided sampling of peripheral pulmonary lesions compares favorably with results from sizable nonrobotic #bronchoscopy studies.
Read more in the August #JournalCHEST issue: hubs.la/Q03Cql920


English
GS_Bronch retweetledi

Topic ideas due tomorrow at 2PM CT! Help make #CHEST2026 a clinically relevant learning experience for you. Submit now:
hubs.la/Q03WhklJ0

English
GS_Bronch retweetledi

Only a few hours left! ⏰ Tune in to this webinar today, December 2, as a multidisciplinary team delves into the practice-changing non-small cell lung cancer studies reported on at this year’s national and international cancer meetings. Register: hubs.la/Q03Wv3QS0
#NSCLC

English
GS_Bronch retweetledi

In case you missed it, the recording of our webinar yesterday, “Components Necessary for High-Quality Lung Cancer Screening”, is now available: youtu.be/lHtAgjFwxDI

YouTube

English
GS_Bronch retweetledi

Gain more insight on treatment for stage III non-small cell lung cancer (#NSCLC), including adjuvant targeted therapy after surgical resection and neoadjuvant chemoimmunotherapy before surgery. Watch the webinar today:
hubs.la/Q03WWp070

English
GS_Bronch retweetledi

INSIDE LOOK 👀 Read from the upcoming issue (December 9): A CHEST research letter compares the currently described methods of identifying CT scan lesion location within the lung.
Read more in the journal CHEST®: hubs.la/Q03VjqGG0
#MedEd #JournalCHEST #LungCancer

English
GS_Bronch retweetledi

Great session at CHEST 2025 to discuss changes and implementation challenges of TNM-9 Staging of Lung Cancer. @accpchest @AAB_IP @wabipconnect @DukePulmFellows @DukeSurgery @DukeCancer @DukeCancerNTWK @DukePACC




English
GS_Bronch retweetledi

CHEST® Pulmonary Editor in Chief @DrMCMiles, other editors, and authors will highlight recent research from CHEST's journal portfolio during #CHEST2025.
🔗 Read more in CHEST 2025: Inside Look: hubs.la/Q03Pf1Xt0

English
GS_Bronch retweetledi

📣Call for Papers! 📣
Looking for articles highlighting the spectrum of discovery in thoracic malignancies
📅Deadline: October 28, 2025
🔬Learn More Here: tinyurl.com/yc3f9r7y
🖱️Submit here:tinyurl.com/3h7dmm2x
@atscommunity @atstoa

English
GS_Bronch retweetledi

Discover the latest diagnostic algorithms for early-stage NSCLC, and stay up to date with current expert recommendations, research findings, and best practices. Watch the webinar on demand now:
hubs.la/Q03JqNmk0
#NSCLC

English
GS_Bronch retweetledi

Discover unparalleled opportunities and connect with employers from across the nation at CHEST Career Fair. #CHEST2025 registrants can attend this enriching, in-person experience for free. Sign up now: hubs.la/Q03KD_5T0

English